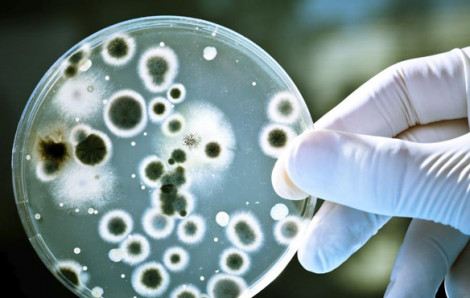
Nhiều thách thức đối với việc kiểm soát nhiễm khuẩn bệnh viện

Kết quả tìm kiếm cho "nhiem khuan benh vien"
Kết quả 1 - 12 trong khoảng 32

Ngày 26/1, Bệnh viện Bệnh Nhiệt đới Trung ương cho biết vừa tiếp nhận 1 ca bệnh dễ bị nhầm lẫn liên cầu khuẩn.

Kiểm soát nhiễm khuẩn có vai trò then chốt trong hoạt động điều trị tổng thể của người bệnh, liên quan mật thiết đến kết quả điều trị.

Bà D.T.L. (73 tuổi, ở Phú Thọ) nhập viện trong tình trạng nguy kịch, sau khi tiêm thuốc giảm đau vùng cổ tại một cơ sở y tế địa phương.

Sau khi tự nặn mụn nhọt ở ngón chân, người đàn ông ở Nam Định nhập viện trong tình trạng khó thở, lơ mơ, gọi hỏi không đáp ứng.

Từ một vết thương nhỏ ở bàn chân khi làm đồng, người đàn ông ở Lào Cai nguy kịch vì suy gan, suy thận...

Ngày 27/6, Bệnh viện Bệnh Nhiệt đới Trung ương cảnh báo về thói quen tưởng chừng “vô hại” của nhiều người trẻ, có thể dẫn tới hậu quả nặng nề.

Sau khi tiêm thuốc đau khớp vai, người phụ nữ sốt cao, sưng nề vai và rơi vào tình trạng nguy hiểm tính mạng.

1 trong 10 người bệnh bị ảnh hưởng sẽ không qua khỏi do nhiễm khuẩn bệnh viện…

Dự báo đến năm 2050, gần 3,5 triệu người trên thế giới có thể tử vong do nhiễm khuẩn bệnh viện mỗi năm.

Sau khi dán cao, xoa dầu vào chân bị chấn thương, người đàn ông bất ngờ tím đen, hoại tử chân. Nguyên nhân từ loại vi khuẩn gây nhiễm độc chết người...
Bộ Y tế đặt mục tiêu, trong giai đoạn 2025-2030 phải nâng cao năng lực phòng và kiểm soát nhiễm khuẩn trong các cơ sở khám, chữa bệnh.

Đây là chỉ tiêu mà Bộ Y tế đặt ra đến năm 2025 nhằm phòng, chống kháng thuốc.